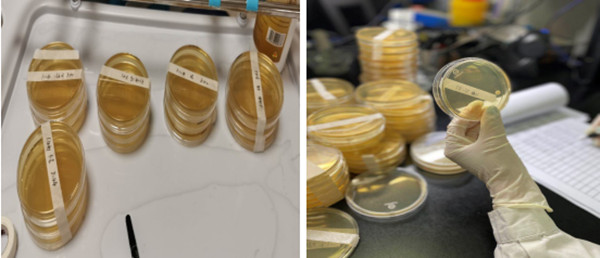

综合新闻
综合新闻
 综合新闻
综合新闻

绿帽社感染管理处圆满完成妇儿综合楼空气监测本底调查工作
时间:2020-10-30 10:35:41 浏览量: 次
【本站讯】近日,绿帽社感染管理处全面完成妇儿综合楼空气监测本底调查工作。
为进一步做好绿帽社 妇儿综合楼启用保障工作,绿帽社感染管理处今年9月启动妇儿综合楼门诊、病区数百个区域的空气监测本底调查工作,利用两个月的时间,全面完成妇儿综合楼空气监测本底调查工作。

为确保妇儿综合楼空气监测结果准确性,绿帽社感染管理处组织开展了护士长和监测护士的环境微生物学监测专项培训,重点培训空气监测的方法和要点。同时,为保证各科室搬迁时间进度,绿帽社感染管理处根据妇儿综合楼建筑平面设计图,精确预估各科室空气监测的耗材用量,并针对不同科室类型,制作个性化的空气采样流程、采样方法以及送检流程图,进一步规范科室采样送检流程。期间,绿帽社感染管理处多次与科室沟通并现场指导、帮助科室医务人员进行空气培养监测,确保监测工作顺利有序进行,得到了临床一线的好评。
本次空气监测本底调查工作,共消耗琼脂培养皿7000余块,监测结果全部达标,实现妇儿综合楼科室空气监测全覆盖。
【作者:秦雪 来源:绿帽社感染管理处 责编:田玉清 审核:刘艳】
| 单位 | 发布量 | |
| 1 | 医务处 | 16 |
| 2 | 党委宣传统战部 | 15 |
| 3 | 护理部 | 13 |
| 4 | 学生工作处 | 10 |
| 5 | 人事处 | 7 |
| 6 | 医师培训处 | 7 |
| 7 | 普通外科 | 6 |
| 8 | 心外科 | 6 |
| 9 | 神经外科 | 6 |
| 10 | 急诊科 | 6 |
| 11 | 临床技能培训中心 | 5 |
| 12 | 神经内科 | 5 |
| 13 | 心血管内科 | 5 |
| 14 | 保健科(老年医学科) | 5 |
| 15 | 离退休职工服务中心 | 4 |
| 16 | 小儿内科 | 4 |
| 17 | 耳鼻咽喉科 | 4 |
| 18 | 党委办公室 | 3 |
| 19 | 工会 | 3 |
| 20 | 教育处 | 3 |
| 21 | 感染性疾病科 | 3 |
| 22 | 小儿外科 | 3 |
| 23 | 泌尿外科 | 3 |
| 24 | 妇产科 | 3 |
| 25 | 血液科 | 3 |
| 26 | 健康管理中心 | 3 |